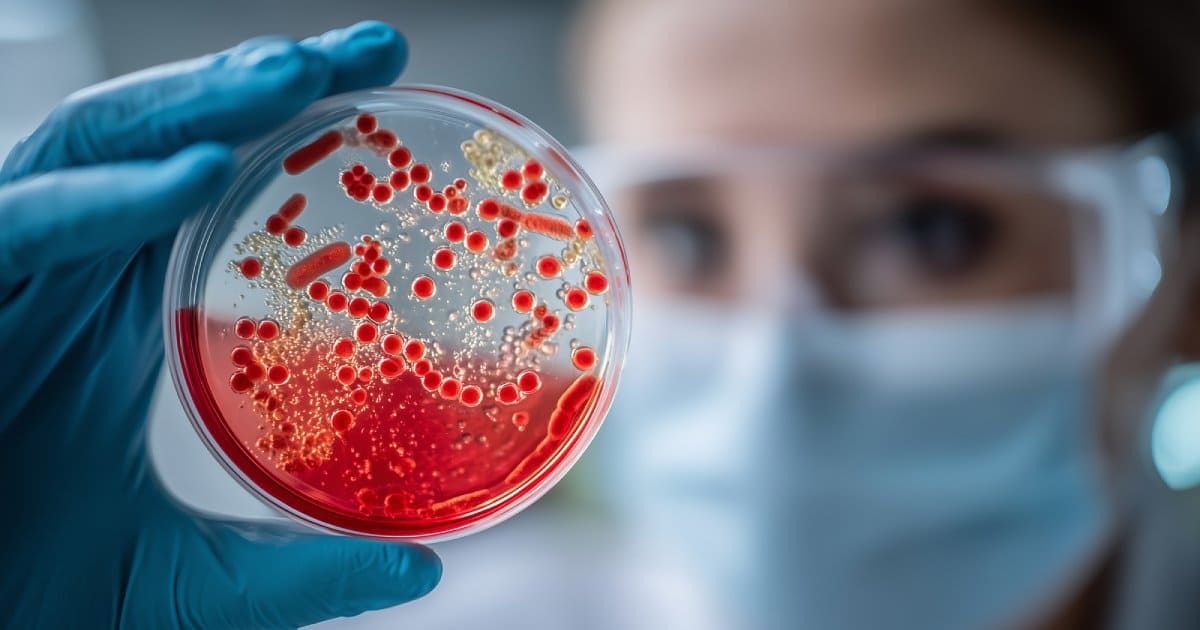

LAU Research Highlights the Prevalence of Antimicrobial Resistance in Lebanon
A recent study into antimicrobial resistance in Lebanon by faculty at the Gilbert and Rose-Marie Chagoury School of Medicine can well inform a national control strategy.
Antimicrobial medicines, especially antibiotics, play a crucial role in our healthcare system today. However, their frequent or improper use can lead to bacteria adapting in ways that diminish their effectiveness, resulting in antimicrobial resistance.
As this can leave doctors with fewer dependable options, transforming what should be a straightforward medical issue into a more complex and risky challenge. In response, many countries implement control strategies aimed at mitigating the impacts of antimicrobial resistance.
A new Lebanon-wide study in the International Journal of Infectious Diseases, led by Dr. Rima Moghnieh, clinical professor at the Gilbert and Rose-Marie Chagoury School of Medicine, puts an important building block for such a control strategy in Lebanon.
Working with co-authors from universities, hospitals and laboratories across Lebanon, the team explored the antimicrobial resistance for Staphylococcus aureus (S.aureus), a common bacterium that can cause skin and bloodstream infections. To do so, the team compiled “antibiograms,” namely hospital laboratory summaries showing which antibiotics tend to work against specific bacteria. Over the course of seven years (2017 to 2023), the team collected 6,959 nonduplicate S. aureus samples from 13 hospitals.
Overall, 36.9 percent of samples were MRSA (Methicillin-resistant Staphylococcus aureus), a type of S. aureus bacterium that is resistant to the standard methicillin antibiotic and is often more difficult to treat. About 9.7 percent of all samples were resistant to multiple antibiotic groups, and as expected, MRSA was significantly more resistant than non-MRSA to many antibiotic groups.
Furthermore, samples from inpatients had significantly higher methicillin resistance than outpatients, as well as higher resistance to a few other commonly used options. At the same time, outpatients showed significantly higher resistance to fluoroquinolones, a widely used antibiotic family for infections, such as urinary and respiratory infections.
This “suggests that resistant Staphylococcus aureus is well established in the community, likely driven by widespread antibiotic exposure, which blurs the traditional separation between inpatient and outpatient resistance profiles,” noted Dr. Moghnieh.
Tracking the general trend in Lebanon, the study showed that over the seven years, methicillin resistance rose significantly, from 34.4 percent in 2017 to 43.2 percent in 2023. Resistance to fluoroquinolones increased sharply and significantly, from 21.6 percent to 54.8 percent. Multidrug resistance also increased significantly over time.
However, although the overall rate of S. aureus acquisition stayed stable, bloodstream infections told a different story, increasing significantly per 1,000 admissions before dipping in the final year. This is not a minor detail as it “suggests a shift toward more severe or invasive disease rather than increased transmission alone,” said Dr. Moghnieh.
These findings, she added, “indicate that while the overall presence of S. aureus has not increased, the clinical impact and severity of infections have worsened, highlighting the need for strengthened surveillance, infection control, and targeted antimicrobial stewardship.”
In conclusion, the researchers call for developing and implementing a national strategy, in an effort to reinforce infection prevention measures and advance targeted antimicrobial stewardship. The evidence-based insights provided by the study may very well be a first step toward making that possible.